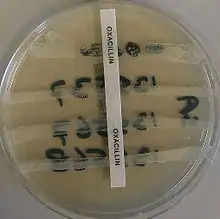

Methicillin-resistant Staphylococcus aureus
Methicillin-resistant Staphylococcus aureus (MRSA) refers to a group of Gram-positive bacteria that are genetically distinct from other strains of Staphylococcus aureus. MRSA is responsible for several difficult-to-treat infections in humans. MRSA is any strain of S. aureus that has developed (through natural selection) or acquired (through horizontal gene transfer) a multiple drug resistance to beta-lactam antibiotics. Beta-lactam (β-lactam) antibiotics are a broad-spectrum group that include some penams (penicillin derivatives such as methicillin and oxacillin) and cephems such as the cephalosporins.[1] Strains unable to resist these antibiotics are classified as methicillin-susceptible S. aureus, or MSSA.

MRSA is common in hospitals, prisons, and nursing homes, where people with open wounds, invasive devices such as catheters, and weakened immune systems are at greater risk of hospital-acquired infection. MRSA began as a hospital-acquired infection but has become community-acquired, as well as livestock-acquired. The terms HA-MRSA (healthcare-associated or hospital-acquired MRSA), CA-MRSA (community-associated MRSA), and LA-MRSA (livestock-associated MRSA) reflect this.
Signs and symptoms

In humans, Staphylococcus aureus is part of the normal microbiota present in the upper respiratory tract,[2] and on skin and in the gut mucosa.[3] However, along with similar bacterial species that can colonize and act symbiotically, they can cause disease if they begin to take over the tissues they have colonized or invade other tissues; the resultant infection has been called a "pathobiont".[2]
After 72 hours, MRSA can take hold in human tissues and eventually become resistant to treatment. The initial presentation of MRSA is small red bumps that resemble pimples, spider bites, or boils; they may be accompanied by fever and, occasionally, rashes. Within a few days, the bumps become larger and more painful; they eventually open into deep, pus-filled boils. About 75 percent of CA-MRSA infections are localized to skin and soft tissue and usually can be treated effectively.[4]
Risk factors
A select few of the populations at risk include:
- People with indwelling implants, prostheses, drains, and catheters[1][5]
- People who are frequently in crowded places, especially with shared equipment and skin-to-skin contact[6]
- People with weak immune systems (HIV/AIDS, lupus, or cancer sufferers; transplant recipients; severe asthmatics; etc.)
- Diabetics[1][7]
- Intravenous drug users[8][9]
- Regular contact with someone who used drugs in the past year[10]
- Users of quinolone antibiotics[5][11]
- Elderly people[5][12]
- School children sharing sports and other equipment
- College students living in dormitories[6]
- People staying or working in a health-care facility for an extended period of time[5][6]
- People who spend time in coastal waters where MRSA is present, such as some beaches in Florida and the West Coast of the United States[13][14]
- People who spend time in confined spaces with other people, including occupants of homeless shelters, prison inmates, and military recruits in basic training[15][16]
- Veterinarians, livestock handlers, and pet owners[17]
- People who ingest unpasteurized milk[18]
- People who are immunocompromised and also colonized[19]:249
- People with chronic obstructive pulmonary disease[5]
- People who have had thoracic surgery[5]
As many as 22% of people infected with MRSA do not have any discernable risk factors.[20]:637
Hospitalized people
People who are hospitalized, including the elderly, are often immunocompromised and susceptible to infection of all kinds, including MRSA; an infection by MRSA is called healthcare-associated or hospital-acquired methicillin-resistant S. aureus (HA-MRSA).[1][5][21][22] Generally, those infected by MRSA stay infected for just under 10 days, if treated by a doctor, although effects may vary from person to person.[23]
Both surgical and nonsurgical wounds can be infected with HA-MRSA.[1][5][21] Surgical site infections occur on the skin surface, but can spread to internal organs and blood to cause sepsis.[1] Transmission can occur between healthcare providers and patients because some providers may neglect to perform preventative hand-washing between examinations.[11][24]
People in nursing homes are at risk for all the reasons above, further complicated by their generally weaker immune systems.[12][25]
Prison inmates and military personnel
Prisons and military barracks[18] can be crowded and confined, and poor hygiene practices may proliferate, thus putting inhabitants at increased risk of contracting MRSA.[17] Cases of MRSA in such populations were first reported in the United States and later in Canada. The earliest reports were made by the Centers for Disease Control and Prevention in US state prisons. In the news media, hundreds of reports of MRSA outbreaks in prisons appeared between 2000 and 2008. For example, in February 2008, the Tulsa County jail in Oklahoma started treating an average of 12 S. aureus cases per month.[26]
Animals
Antibiotic use in livestock increases the risk that MRSA will develop among the livestock; strains MRSA ST 398 and CC398 are transmissible to humans.[18][27] Generally, animals are asymptomatic.[1]
Domestic pets are susceptible to MRSA infection by transmission from their owners; conversely, MRSA-infected pets can also transmit MRSA to humans.[28]
Athletes
Locker rooms, gyms, and related athletic facilities offer potential sites for MRSA contamination and infection.[29] Athletes have been identified as a high-risk group.[18] A study linked MRSA to the abrasions caused by artificial turf.[30] Three studies by the Texas State Department of Health found the infection rate among football players was 16 times the national average. In October 2006, a high-school football player was temporarily paralyzed from MRSA-infected turf burns. His infection returned in January 2007 and required three surgeries to remove infected tissue, and three weeks of hospital stay.[31]
In 2013, Lawrence Tynes, Carl Nicks, and Johnthan Banks of the Tampa Bay Buccaneers were diagnosed with MRSA. Tynes and Nicks apparently did not contract the infection from each other, but whether Banks contracted it from either individual is unknown.[32] In 2015, Los Angeles Dodgers infielder Justin Turner was infected while the team visited the New York Mets.[33] In October 2015, New York Giants tight end Daniel Fells was hospitalized with a serious MRSA infection.[34]
Children
MRSA is becoming a critical problem in children;[35] studies found 4.6% of patients in U.S. health-care facilities, (presumably) including hospital nurseries,[36] were infected or colonized with MRSA.[37] Children and adults who come in contact with day-care centers,[18] playgrounds, locker rooms, camps, dormitories, classrooms and other school settings, and gyms and workout facilities are at higher risk of contracting MRSA. Parents should be especially cautious of children who participate in activities where sports equipment is shared, such as football helmets and uniforms.[38]
Injection Drug Abusers
Needle-required drugs have caused an increase of MRSA,[39] with injection drug use (IDU) making up 24.1% (1,839 individuals) of Tennessee Hospital's Discharge System. The unsanitary methods of injection causes an access point for the MRSA to enter the blood stream and begin infecting the host. Furthermore, with MRSA's high contagion rate,[10] a common risk factor is individuals who are in constant contact with someone who has injected drugs in the past year. This does still depend how strong the non-infected individual's immune system is and how long both individuals remain in contact.
Mechanism
Antimicrobial resistance is genetically based; resistance is mediated by the acquisition of extrachromosomal genetic elements containing genes that confer resistance to certain antibiotics. Examples of such elements include plasmids, transposable genetic elements, and genomic islands, which can be transferred between bacteria through horizontal gene transfer.[40] A defining characteristic of MRSA is its ability to thrive in the presence of penicillin-like antibiotics, which normally prevent bacterial growth by inhibiting synthesis of cell wall material. This is due to a resistance gene, mecA, which stops β-lactam antibiotics from inactivating the enzymes (transpeptidases) critical for cell wall synthesis.[41]
SCCmec
Staphylococcal cassette chromosome mec (SCCmec) is a genomic island of unknown origin containing the antibiotic resistance gene mecA.[42][43] SCCmec contains additional genes beyond mecA, including the cytolysin gene psm-mec, which may suppress virulence in HA-acquired MRSA strains.[44] In addition, this locus encodes strain-dependent gene regulatory RNAs known as psm-mecRNA.[45] SCCmec also contains ccrA and ccrB; both genes encode recombinases that mediate the site-specific integration and excision of the SCCmec element from the S. aureus chromosome.[42][43] Currently, six unique SCCmec types ranging in size from 21–67 kb have been identified;[42] they are designated types I–VI and are distinguished by variation in mec and ccr gene complexes.[40] Owing to the size of the SCCmec element and the constraints of horizontal gene transfer, a minimum of five clones are thought to be responsible for the spread of MRSA infections, with clonal complex (CC) 8 most prevalent.[42][46] SCCmec is thought to have originated in the closely related Staphylococcus sciuri species and transferred horizontally to S. aureus.[47]
Different SCCmec genotypes confer different microbiological characteristics, such as different antimicrobial resistance rates.[48] Different genotypes are also associated with different types of infections. Types I–III SCCmec are large elements that typically contain additional resistance genes and are characteristically isolated from HA-MRSA strains.[43][48] Conversely, CA-MRSA is associated with types IV and V, which are smaller and lack resistance genes other than mecA.[43][48]
These distinctions were thoroughly investigated by Collins et al. in 2001, and can be explained by the fitness differences associated with carriage of a large or small SCCmec plasmid. Carriage of large plasmids, such as SCCmecI–III, is costly to the bacteria, resulting in a compensatory decrease in virulence expression.[49] MRSA is able to thrive in hospital settings with increased antibiotic resistance but decreased virulence – HA-MRSA targets immunocompromised, hospitalized hosts, thus a decrease in virulence is not maladaptive.[49] In contrast, CA-MRSA tends to carry lower-fitness cost SCCmec elements to offset the increased virulence and toxicity expression required to infect healthy hosts.[49]
mecA
mecA is a biomarker gene responsible for resistance to methicillin and other β-lactam antibiotics. After acquisition of mecA, the gene must be integrated and localized in the S. aureus chromosome.[42] mecA encodes penicillin-binding protein 2a (PBP2a), which differs from other penicillin-binding proteins as its active site does not bind methicillin or other β-lactam antibiotics.[42] As such, PBP2a can continue to catalyze the transpeptidation reaction required for peptidoglycan cross-linking, enabling cell wall synthesis even in the presence of antibiotics. As a consequence of the inability of PBP2a to interact with β-lactam moieties, acquisition of mecA confers resistance to all β-lactam antibiotics in addition to methicillin.[42][50]
mecA is under the control of two regulatory genes, mecI and mecR1. MecI is usually bound to the mecA promoter and functions as a repressor.[40][43] In the presence of a β-lactam antibiotic, MecR1 initiates a signal transduction cascade that leads to transcriptional activation of mecA.[40][43] This is achieved by MecR1-mediated cleavage of MecI, which alleviates MecI repression.[40] mecA is further controlled by two co-repressors, blaI and blaR1. blaI and blaR1 are homologous to mecI and mecR1, respectively, and normally function as regulators of blaZ, which is responsible for penicillin resistance.[42][51] The DNA sequences bound by mecI and blaI are identical;[42] therefore, blaI can also bind the mecA operator to repress transcription of mecA.[51]
Arginine catabolic mobile element
The arginine catabolic mobile element (ACME) is a virulence factor present in many MRSA strains but not prevalent in MSSA.[52] SpeG-positive ACME compensates for the polyamine hypersensitivity of S. aureus and facilitates stable skin colonization, wound infection, and person-to-person transmission.[53]
Strains

Acquisition of SCCmec in methicillin-sensitive S. aureus (MSSA) gives rise to a number of genetically different MRSA lineages. These genetic variations within different MRSA strains possibly explain the variability in virulence and associated MRSA infections.[54] The first MRSA strain, ST250 MRSA-1, originated from SCCmec and ST250-MSSA integration.[54] Historically, major MRSA clones ST2470-MRSA-I, ST239-MRSA-III, ST5-MRSA-II, and ST5-MRSA-IV were responsible for causing hospital-acquired MRSA (HA-MRSA) infections.[54] ST239-MRSA-III, known as the Brazilian clone, was highly transmissible compared to others and distributed in Argentina, Czech Republic, and Portugal.[54]
In the UK, the most common strains of MRSA are EMRSA15 and EMRSA16.[55] EMRSA16 has been found to be identical to the ST36:USA200 strain, which circulates in the United States, and to carry the SCCmec type II, enterotoxin A and toxic shock syndrome toxin 1 genes.[56] Under the new international typing system, this strain is now called MRSA252. EMRSA 15 is also found to be one of the common MRSA strains in Asia. Other common strains include ST5:USA100 and EMRSA 1.[57] These strains are genetic characteristics of HA-MRSA.[58]
Community-acquired MRSA (CA-MRSA) strains emerged in late 1990 to 2000, infecting healthy people who had not been in contact with healthcare facilities.[58] Researchers suggest that CA-MRSA did not evolve from HA-MRSA.[58] This is further proven by molecular typing of CA-MRSA strains[59] and genome comparison between CA-MRSA and HA-MRSA, which indicate that novel MRSA strains integrated SCCmec into MSSA separately on its own.[58] By mid-2000, CA-MRSA was introduced into healthcare systems and distinguishing CA-MRSA from HA-MRSA became a difficult process.[58] Community-acquired MRSA is more easily treated and more virulent than hospital-acquired MRSA (HA-MRSA).[58] The genetic mechanism for the enhanced virulence in CA-MRSA remains an active area of research. The Panton–Valentine leukocidin (PVL) genes are of particular interest because they are a unique feature of CA-MRSA.[54]
In the United States, most cases of CA-MRSA are caused by a CC8 strain designated ST8:USA300, which carries SCCmec type IV, Panton–Valentine leukocidin, PSM-alpha and enterotoxins Q and K,[56] and ST1:USA400.[60] The ST8:USA300 strain results in skin infections, necrotizing fasciitis, and toxic shock syndrome, whereas the ST1:USA400 strain results in necrotizing pneumonia and pulmonary sepsis.[54] Other community-acquired strains of MRSA are ST8:USA500 and ST59:USA1000. In many nations of the world, MRSA strains with different genetic background types have come to predominate among CA-MRSA strains; USA300 easily tops the list in the U.S. and is becoming more common in Canada after its first appearance there in 2004. For example, in Australia, ST93 strains are common, while in continental Europe ST80 strains, which carry SCCmec type IV, predominate.[61][62] In Taiwan, ST59 strains, some of which are resistant to many non-beta-lactam antibiotics, have arisen as common causes of skin and soft tissue infections in the community. In a remote region of Alaska, unlike most of the continental U.S., USA300 was found only rarely in a study of MRSA strains from outbreaks in 1996 and 2000 as well as in surveillance from 2004–06.[63]
A MRSA strain, CC398, is found in intensively reared production animals (primarily pigs, but also cattle and poultry), where it can be transmitted to humans as LA-MRSA (livestock-associated MRSA).[57][64][65]
Diagnosis

Diagnostic microbiology laboratories and reference laboratories are key for identifying outbreaks of MRSA. Normally, a bacterium must be cultured from blood, urine, sputum, or other body-fluid samples, and in sufficient quantities to perform confirmatory tests early-on. Still, because no quick and easy method exists to diagnose MRSA, initial treatment of the infection is often based upon "strong suspicion" and techniques by the treating physician; these include quantitative PCR procedures, which are employed in clinical laboratories for quickly detecting and identifying MRSA strains.[66][67]
Another common laboratory test is a rapid latex agglutination test that detects the PBP2a protein. PBP2a is a variant penicillin-binding protein that imparts the ability of S. aureus to be resistant to oxacillin.[68]
Microbiology
Like all S. aureus (also abbreviated SA at times), methicillin-resistant S. aureus is a Gram-positive, spherical (coccus) bacterium about 1 micron in diameter. It does not form spores and it is not motile. It is frequently found in grape-like clusters or chains.[69]:390 Unlike methicillin-susceptible S. aureus (MSSA), MRSA is slow-growing on a variety of media and has been found to exist in mixed colonies of MSSA. The mecA gene, which confers resistance to a number of antibiotics, is always present in MRSA and usually absent in MSSA; however, in some instances, the mecA gene is present in MSSA but is not expressed. Polymerase chain reaction (PCR) testing is the most precise method for identifying MRSA strains. Specialized culture media have been developed to better differentiate between MSSA and MRSA and, in some cases, such media can be used to identify specific strains that are resistant to different antibiotics.[69]:402
Other strains of S. aureus have emerged that are resistant to oxacillin, clindamycin, teicoplanin, and erythromycin. These resistant strains may or may not possess the mecA gene. S. aureus has also developed resistance to vancomycin (VRSA). One strain is only partially susceptible to vancomycin and is called vancomycin-intermediate S. aureus (VISA). GISA, a strain of resistant S. aureus, is glycopeptide-intermediate S. aureus and is less suspectible to vancomycin and teicoplanin. Resistance to antibiotics in S. aureus can be quantified by determining the amount of the antibiotic that must be used to inhibit growth. If S. aureus is inhibited at a concentration of vancomycin less than or equal to 4 μg/ml, it is said to be susceptible. If a concentration greater than 32 μg/ml is necessary to inhibit growth, it is said to be resistant.[20]:637
Prevention
Screening
In health-care settings, isolating those with MRSA from those without the infection is one method to prevent transmission. Rapid culture and sensitivity testing and molecular testing identifies carriers and reduces infection rates.[70]
MRSA can be identified by swabbing the nostrils and isolating the bacteria found there. Combined with extra sanitary measures for those in contact with infected people, swab screening people admitted to hospitals has been found to be effective in minimizing the spread of MRSA in hospitals in the United States, Denmark, Finland, and the Netherlands.[71]
Handwashing
The Centers for Disease Control and Prevention offers suggestions for preventing the contraction and spread of MRSA infection which are applicable to those in community settings, including incarcerated populations, childcare center employees, and athletes. To prevent the spread of MRSA, the recommendations are to wash hands thoroughly and regularly using soap and water or an alcohol-based sanitizer. Additional recommendations are to keep wounds clean and covered, avoid contact with other people's wounds, avoid sharing personal items such as razors or towels, shower after exercising at athletic facilities, and shower before using swimming pools or whirlpools.[72]
Isolation
Excluding medical facilities, current US guidance does not require workers with MRSA infections to be routinely excluded from the general workplace.[73] The National Institutes of Health recommend that those with wound drainage that cannot be covered and contained with a clean, dry bandage and those who cannot maintain good hygiene practices be reassigned.[73] Workers with active infections are excluded from activities where skin-to-skin contact is likely to occur.[74] To prevent the spread of staphylococci or MRSA in the workplace, employers are encouraged to make available adequate facilities that support good hygiene. In addition, surface and equipment sanitizing should conform to Environmental Protection Agency-registered disinfectants.[73] In hospital settings, contact isolation can be stopped after one to three cultures come back negative.[75]
To prevent the spread of MRSA in the home, health departments recommend laundering materials that have come into contact with infected persons separately and with a dilute bleach solution; to reduce the bacterial load in one's nose and skin; and to clean and disinfect those things in the house that people regularly touch, such as sinks, tubs, kitchen counters, cell phones, light switches, doorknobs, phones, toilets, and computer keyboards.[76]
Restricting antibiotic use
Glycopeptides, cephalosporins, and in particular, quinolones are associated with an increased risk of colonisation of MRSA. Reducing use of antibiotic classes that promote MRSA colonisation, especially fluoroquinolones, is recommended in current guidelines.[11][24]
Public health considerations
Mathematical models describe one way in which a loss of infection control can occur after measures for screening and isolation seem to be effective for years, as happened in the UK. In the "search and destroy" strategy that was employed by all UK hospitals until the mid-1990s, all hospitalized people with MRSA were immediately isolated, and all staff were screened for MRSA and were prevented from working until they had completed a course of eradication therapy that was proven to work. Loss of control occurs because colonised people are discharged back into the community and then readmitted; when the number of colonised people in the community reaches a certain threshold, the "search and destroy" strategy is overwhelmed.[77] One of the few countries not to have been overwhelmed by MRSA is the Netherlands: an important part of the success of the Dutch strategy may have been to attempt eradication of carriage upon discharge from hospital.[78]
Decolonization
As of 2013, no randomized clinical trials had been conducted to understand how to treat nonsurgical wounds that had been colonized, but not infected, with MRSA,[21] and insufficient studies had been conducted to understand how to treat surgical wounds that had been colonized with MRSA.[1] As of 2013, whether strategies to eradicate MRSA colonization of people in nursing homes reduced infection rates was not known.[25]
Care should be taken when trying to drain boils, as disruption of surrounding tissue can lead to larger infections, including infection of the blood stream.[79] Mupirocin 2% ointment can be effective at reducing the size of lesions. A secondary covering of clothing is preferred.[76] As shown in an animal study with diabetic mice, the topical application of a mixture of sugar (70%) and 3% povidone-iodine paste is an effective agent for the treatment of diabetic ulcers with MRSA infection.[80]
Community settings
Maintaining the necessary cleanliness may be difficult for people if they do not have access to facilities such as public toilets with handwashing facilities. In the United Kingdom, the Workplace (Health, Safety and Welfare) Regulations 1992[81] require businesses to provide toilets for their employees, along with washing facilities including soap or other suitable means of cleaning. Guidance on how many toilets to provide and what sort of washing facilities should be provided alongside them is given in the Workplace (Health, Safety and Welfare) Approved Code of Practice and Guidance L24, available from Health and Safety Executive Books, but no legal obligations exist on local authorities in the United Kingdom to provide public toilets, and although in 2008, the House of Commons Communities and Local Government Committee called for a duty on local authorities to develop a public toilet strategy,[82] this was rejected by the Government.[83]
Agriculture
The World Health Organization advocates regulations on the use of antibiotics in animal feed to prevent the emergence of drug-resistant strains of MRSA.[27] MRSA is established in animals and birds.[18]
Treatment
Antibiotics
Treatment of MRSA infection is urgent and delays can be fatal.[19]:328 The location and history related to the infection determines the treatment. The route of administration of an antibiotic varies. Antibiotics effective against MRSA can be given by IV, oral, or a combination of both, and depend on the specific circumstances and patient characteristics.[4] The use of concurrent treatment with vancomycin or other beta-lactam agents may have a synergistic effect.[20]:637
Both CA-MRSA and HA-MRSA are resistant to traditional anti-staphylococcal beta-lactam antibiotics, such as cephalexin. CA-MRSA has a greater spectrum of antimicrobial susceptibility to sulfa drugs (like co-trimoxazole (trimethoprim/sulfamethoxazole), tetracyclines (like doxycycline and minocycline) and clindamycin (for osteomyelitis).[4] MRSA can be eradicated with a regimen of linezolid,[84] though treatment protocols vary and serum levels of antibiotics vary widely from person to person and may affect outcomes.[85] The effective treatment of MRSA with linezolid has been successful[84] in 87% of people. Linezolid is more effective in soft tissue infections than vancomycin.[86][1] This is compared to eradication of infection in those with MRSA treated with vancomycin. Treatment with vancomycin is successful in approximately 49% of people.[1] Linezolid belongs to the newer oxazolidinone class of antibiotics which has been shown to be effective against both CA-MRSA and HA-MRSA. The Infectious Disease Society of America recommends vancomycin, linezolid, or clindamycin (if susceptible) for treating those with MRSA pneumonia.[4] Ceftaroline, a fifth-generation cephalosporin, is the first beta-lactam antibiotic approved in the US to treat MRSA infections in skin and soft tissue or community-acquired pneumonia.[87]
Vancomycin and teicoplanin are glycopeptide antibiotics used to treat MRSA infections.[88] Teicoplanin is a structural congener of vancomycin that has a similar activity spectrum but a longer half-life.[89] Because the oral absorption of vancomycin and teicoplanin is very low, these agents can be administered intravenously to control systemic infections.[90] Treatment of MRSA infection with vancomycin can be complicated, due to its inconvenient route of administration. Moreover, the efficacy of vancomycin against MRSA is inferior to that of anti-staphylococcal beta-lactam antibiotics against methicillin-susceptible S. aureus (MSSA).[91][92]
Several newly discovered strains of MRSA show antibiotic resistance even to vancomycin and teicoplanin. These new strains of the MRSA bacterium have been dubbed vancomycin intermediate-resistant S. aureus (VISA).[93] [94] Linezolid, quinupristin/dalfopristin, daptomycin, ceftaroline, and tigecycline are used to treat more severe infections that do not respond to glycopeptides such as vancomycin.[95] Current guidelines recommend daptomycin for VISA bloodstream infections and endocarditis.[4]
This left vancomycin as the only effective agent available at the time. However, strains with intermediate (4–8 μg/ml) levels of resistance, termed glycopeptide-intermediate S. aureus (GISA) or vancomycin-intermediate S. aureus (VISA), began appearing in the late 1990s. The first identified case was in Japan in 1996, and strains have since been found in hospitals in England, France, and the US. The first documented strain with complete (>16 μg/ml) resistance to vancomycin, termed vancomycin-resistant S. aureus (VRSA) appeared in the United States in 2002.[96] However, in 2011, a variant of vancomycin was tested that binds to the lactate variation and also binds well to the original target, thus reinstating potent antimicrobial activity.[97]
Oxazolidinones such as linezolid became available in the 1990s and are comparable to vancomycin in effectiveness against MRSA. Linezolid resistance in S. aureus was reported in 2001,[98] but infection rates have been at consistently low levels. In the United Kingdom and Ireland, no resistance was found in staphylococci collected from bacteremia cases between 2001 and 2006.[99]
Skin and soft-tissue infections
In skin abscesses, the primary treatment recommended is removal of dead tissue, incision, and drainage. More information is needed to determine the effectiveness of specific antibiotics therapy in surgical site infections (SSIs).[4] Examples of soft-tissue infections from MRSA include ulcers, impetigo, abscesses, and SSIs.[86] In surgical wounds, evidence is weak (high risk of bias) that linezolid may be better than vancomycin to eradicate MRSA SSIs.[1]
MRSA colonization is also found in nonsurgical wounds such as traumatic wounds, burns, and chronic ulcers (i.e.: diabetic ulcer, pressure ulcer, arterial insufficiency ulcer, venous ulcer). No conclusive evidence has been found about the best antibiotic regimen to treat MRSA colonization.[21]
Children
In skin infections and secondary infection sites, topical mupirocin is used successfully. For bacteremia and endocarditis, vancomycin or daptomycin is considered. For children with MRSA-infected bone or joints, treatment is individualized and long-term. Neonates can develop neonatal pustulosis as a result of topical infection with MRSA.[4] Clindamycin is not approved for the treatment of MRSA infection, but it is still used in children for soft-tissue infections.[4]
Endocarditis and bacteremia
Evaluation for the replacement of a prosthetic valve is considered. Appropriate antibiotic therapy may be administered for up to six weeks. Four to six weeks of antibiotic treatment is often recommended, and is dependent upon the extent of MRSA infection.[4]
Respiratory infections
CA-MRSA in hospitalized patients pneumonia treatment begins before culture results. After the susceptibility to antibiotics is performed, the infection may be treated with vancomycin or linezolid for up to 21 days. If the pneumonia is complicated by the accumulation of pus in the pleural cavity surrounding the lungs, drainage may be done along with antibiotic therapy.[4] People with cystic fibrosis may develop respiratory complications related to MRSA infection. The incidence of MRSA in those with cystic fibrosis increased during 2000 to 2015 by five times. Most of these infections were HA-MRSA. MRSA accounts for 26% of lung infections in those with cystic fibrosis.[100]
There is insufficient evidence to support the use of topical or systematic antibiotics for nasal or extra-nasal MRSA infection.[101]
Bone and joint infections
Cleaning the wound of dead tissue and draining abscesses is the first action to treat the MRSA infection. Administration of antibiotics is not standardized and is adapted by a case-by-case basis. Antibiotic therapy can last up to 3 months and sometimes even longer.[4]
Infected implants
MRSA infection can occur associated with implants and joint replacements. Recommendations on treatment are based upon the length of time the implant has been in place. In cases of a recent placement of a surgical implant or artificial joint, the device may be retained while antibiotic therapy continues. If the placement of the device has occurred over 3 weeks ago, the device may be removed. Antibiotic therapy is used in each instance sometimes long-term.[4]
Central nervous system
MRSA can infect the central nervous system and form brain abscess, subdural empyema, and spinal epidural abscess. Excision and drainage can be done along with antibiotic treatment. Septic thrombosis of cavernous or dural venous sinus can sometimes be a complication.[4]
Other infections
Treatment is not standardized for other instances of MRSA infection in a wide range of tissues. Treatment varies for MRSA infections related to: subperiosteal abscesses, necrotizing pneumonia, cellulitis, pyomyositis, necrotizing fasciitis, mediastinitis, myocardial, perinephric, hepatic, and splenic abscesses, septic thrombophlebitis, and severe ocular infections, including endophthalmitis.[4] Pets can be reservoirs and pass on MRSA to people. In some cases, the infection can be symptomatic and the pet can suffer a MRSA infection. Health departments recommend that the pet be taken to the veterinarian if MRSA infections keep occurring in the people who have contact with the pet.[76]
Epidemiology
Worldwide, an estimated 2 billion people carry some form of S. aureus; of these, up to 53 million (2.7% of carriers) are thought to carry MRSA.[102]
HA-MRSA
In a US cohort study of 1,300 healthy children, 2.4% carried MRSA in their nose.[103] Bacterial sepsis occurs with most (75%) of cases of invasive MRSA infection.[4] In 2009, there were an estimated 463,017 hospitalizations due to MRSA, or a rate of 11.74 per 1,000 hospitalizations.[104] Many of these infections are less serious, but the Centers for Disease Control and Prevention (CDC) estimate that there are 80,461 invasive MRSA infections and 11,285 deaths due to MRSA annually.[105] In 2003, the cost for a hospitalization due to MRSA infection was US$92,363; a hospital stay for MSSA was $52,791.[86]
Infection after surgery is relatively uncommon, but occurs as much as 33% in specific types of surgeries. Infections of surgical sites range from 1% to 33%. MRSA sepsis that occurs within 30 days following a surgical infection has a 15–38% mortality rate; MRSA sepsis that occurs within one year has a mortality rate of around 55%. There may be increased mortality associated with cardiac surgery. There is a rate of 12.9% in those infected with MRSA while only 3% infected with other organisms. SSIs infected with MRSA had longer hospital stays than those who did not.[1]
Globally, MRSA infection rates are dynamic and vary year to year.[106] According to the 2006 SENTRY Antimicrobial Surveillance Program report, the incidence of MRSA bloodstream infections was 35.9 per cent in North America. MRSA blood infections in Latin America was 29%. European incidence was 22.8%. The rate of all MRSA infections in Europe ranged from 50% per cent in Portugal down to 0.8 per cent in Sweden. Overall MRSA infection rates varied in Latin America: Colombia and Venezuela combined had 3%, Mexico had 50%, Chile 38%, Brazil 29%, and Argentina 28%.[86]
The Centers for Disease Control and Prevention (CDC) estimated that about 1.7 million nosocomial infections occurred in the United States in 2002, with 99,000 associated deaths.[107] The estimated incidence is 4.5 nosocomial infections per 100 admissions, with direct costs (at 2004 prices) ranging from $10,500 (£5300, €8000 at 2006 rates) per case (for bloodstream, urinary tract, or respiratory infections in immunocompetent people) to $111,000 (£57,000, €85,000) per case for antibiotic-resistant infections in the bloodstream in people with transplants. With these numbers, conservative estimates of the total direct costs of nosocomial infections are above $17 billion. The reduction of such infections forms an important component of efforts to improve healthcare safety. (BMJ 2007) MRSA alone was associated with 8% of nosocomial infections reported to the CDC National Healthcare Safety Network from January 2006 to October 2007.[108]
The British National Audit Office estimated that the incidence of nosocomial infections in Europe ranges from 4% to 10% of all hospital admissions. As of early 2005, the number of deaths in the United Kingdom attributed to MRSA has been estimated by various sources to lie in the area of 3,000 per year.[109]
In the United States, an estimated 95 million people carry S. aureus in their noses; of these, 2.5 million (2.6% of carriers) carry MRSA.[110] A population review conducted in three U.S. communities showed the annual incidence of CA-MRSA during 2001–2002 to be 18–25.7/100,000; most CA-MRSA isolates were associated with clinically relevant infections, and 23% of people required hospitalization.[111]
CA-MRSA
In a US cohort study of 1,300 healthy children, 2.4% carried MRSA in their noses.[103] There are concerns that the presence of MRSA in the environment may allow resistance to be transferred to other bacteria through phages (viruses that infect bacteria). The source of MRSA could come from hospital waste, farm sewage, or other waste water.[4]
LA-MRSA
Livestock associated MRSA (LA-MRSA) has been observed in Korea, Brazil, Switzerland, Malaysia, India, Great Britain, Denmark, and China.[18]
History

In 1961, the first known MRSA isolates were reported in a British study, and from 1961 to 1967, infrequent hospital outbreaks occurred in Western Europe and Australia,[16] with methicillin then being licensed in England to treat resistant infections. Other reports of MRSA began to be described in the 1970s.[1] Resistance to other antibiotics was documented in some strains of S. aureus. In 1996, vancomycin resistance was reported in Japan.[20]:637 In many countries, outbreaks of MRSA infection were reported to be transmitted between hospitals.[69]:402 The rate had increased to 22% by 1995, and by 1997 the level of hospital S. aureus infections attributable to MRSA had reached 50%.
The first report of community-associated MRSA (CA-MRSA) occurred in 1981, and in 1982, a large outbreak of CA-MRSA occurred among intravenous drug users in Detroit, Michigan.[16] Additional outbreaks of CA-MRSA were reported through the 1980s and 1990s, including outbreaks among Australian Aboriginal populations that had never been exposed to hospitals. In the mid-1990s, scattered reports of CA-MRSA outbreaks among US children were made. While HA-MRSA rates stabilized between 1998 and 2008, CA-MRSA rates continued to rise. A report released by the University of Chicago Children's Hospital comparing two periods (1993–1995 and 1995–1997) found a 25-fold increase in the rate of hospitalizations due to MRSA among children in the United States.[112] In 1999, the University of Chicago reported the first deaths from invasive MRSA among otherwise healthy children in the United States.[16] By 2004, the genome for various strains of MRSA were described.[113]
The observed increased mortality among MRSA-infected people arguably may be the result of the increased underlying morbidity of these people. Several studies, however, including one by Blot and colleagues, that have adjusted for underlying disease still found MRSA bacteremia to have a higher attributable mortality than methicillin-susceptible S. aureus (MSSA) bacteremia.[114]
A population-based study of the incidence of MRSA infections in San Francisco during 2004–05 demonstrated that nearly one in 300 residents suffered from such an infection in the course of a year and that greater than 85% of these infections occurred outside of the healthcare setting.[115] A 2004 study showed that people in the United States with S. aureus infection had, on average, three times the length of hospital stay (14.3 vs. 4.5 days), incurred three times the total cost ($48,824 vs. $14,141), and experienced five times the risk of in-hospital death (11.2% vs 2.3%) than people without this infection.[116] In a meta-analysis of 31 studies, Cosgrove et al.,[117] concluded that MRSA bacteremia is associated with increased mortality as compared with MSSA bacteremia (odds ratio= 1.93; 95% CI = 1.93 ± 0.39).[118] In addition, Wyllie et al. report a death rate of 34% within 30 days among people infected with MRSA, a rate similar to the death rate of 27% seen among MSSA-infected people.[119]
In the US, the CDC issued guidelines on October 19, 2006, citing the need for additional research, but declined to recommend such screening.[120] According to the CDC, the most recent estimates of the incidence of healthcare-associated infections that are attributable to MRSA in the United States indicate a decline in such infection rates. Incidence of MRSA central line-associated blood-stream infections as reported by hundreds of intensive care units decreased 50–70% from 2001–2007.[121] A separate system tracking all hospital MRSA bloodstream infections found an overall 34% decrease between 2005 and 2008.[121] In 2010, vancomycin was the drug of choice.[4]
Across Europe, based mostly on data from 2013, seven countries (Iceland, Norway, Sweden, the Netherlands, Denmark, Finland, and Estonia, from lowest to highest) had low levels of hospital-acquired MRSA infections compared to the others,[122]:92–93 and among countries with higher levels, significant improvements had been made only in Bulgaria, Poland, and the British Isles.[122]:40
A 1,000-year-old eye salve recipe found in the medieval Bald's Leechbook at the British Library, one of the earliest known medical textbooks, was found to have activity against MRSA in vitro and in skin wounds in mice.[123]
In the media
MRSA is frequently a media topic, especially if well-known personalities have announced that they have or have had the infection.[124][125][126] Word of outbreaks of infection appears regularly in newspapers and television news programs. A report on skin and soft-tissue infections in the Cook County jail in Chicago in 2004–05 demonstrated MRSA was the most common cause of these infections among those incarcerated there.[127] Lawsuits filed against those who are accused of infecting others with MRSA are also popular stories in the media.[128][129]
MRSA is the topic of radio programs,[130] television shows,[131][132][133] books,[134] and movies.[135]
Research
Various antibacterial chemical extracts from various species of the sweetgum tree (genus Liquidambar) have been investigated for their activity in inhibiting MRSA. Specifically, these are: cinnamic acid, cinnamyl cinnamate, ethyl cinnamate, benzyl cinnamate, styrene, vanillin, cinnamyl alcohol, 2-phenylpropyl alcohol, and 3-phenylpropyl cinnamate.[136]
The delivery of inhaled antibiotics along with systematic administration to treat MRSA are being developed. This may improve the outcomes of those with cystic fibrosis and other respiratory infections.[100] Phage therapy has been used for years in MRSA in eastern countries, and studies are ongoing in western countries.[137][138]
MRSA will be included in experiments and cultured on the International Space Station to observe the effects of zero gravity on its evolution.[139][140]
A 2015 Cochrane systematic review aimed to assess the effectiveness of wearing gloves, gowns and masks to help stop the spread of MRSA in hospitals, however no eligible studies were identified for inclusion. The review authors concluded that there is a need for randomized controlled trials to be conducted to help determine if the use of gloves, gowns, and masks reduces the transmission of MRSA in hospitals.[141]
References
- Gurusamy KS, Koti R, Toon CD, Wilson P, Davidson BR (August 2013). "Antibiotic therapy for the treatment of methicillin-resistant Staphylococcus aureus (MRSA) infections in surgical wounds". The Cochrane Database of Systematic Reviews (8): CD009726. doi:10.1002/14651858.CD009726.pub2. PMID 23963687.
- Schenck LP, Surette MG, Bowdish DM (November 2016). "Composition and immunological significance of the upper respiratory tract microbiota". FEBS Letters. 590 (21): 3705–3720. doi:10.1002/1873-3468.12455. PMC 7164007. PMID 27730630.
- Wollina U (2017). "Microbiome in atopic dermatitis". Clinical, Cosmetic and Investigational Dermatology. 10: 51–56. doi:10.2147/CCID.S130013. PMC 5327846. PMID 28260936.
- Liu C, Bayer A, Cosgrove SE, Daum RS, Fridkin SK, Gorwitz RJ, et al. (February 2011). "Clinical practice guidelines by the infectious diseases society of america for the treatment of methicillin-resistant Staphylococcus aureus infections in adults and children". Clinical Infectious Diseases. 52 (3): e18-55. doi:10.1093/cid/ciq146. PMID 21208910.
- Sganga G, Tascini C, Sozio E, Carlini M, Chirletti P, Cortese F, et al. (2016). "Focus on the prophylaxis, epidemiology and therapy of methicillin-resistant Staphylococcus aureus surgical site infections and a position paper on associated risk factors: the perspective of an Italian group of surgeons". World Journal of Emergency Surgery. 11 (1): 26. doi:10.1186/s13017-016-0086-1. PMC 4908758. PMID 27307786.
- "General Information About MRSA in the Community". Centers for Disease Control and Prevention. 10 September 2013. Retrieved 9 October 2014.
- Lipsky BA, Tabak YP, Johannes RS, Vo L, Hyde L, Weigelt JA (May 2010). "Skin and soft tissue infections in hospitalised patients with diabetes: culture isolates and risk factors associated with mortality, length of stay and cost". Diabetologia. 53 (5): 914–23. doi:10.1007/s00125-010-1672-5. PMID 20146051. S2CID 5660826.
- Otter JA, French GL (November 2011). "Community-associated meticillin-resistant Staphylococcus aureus strains as a cause of healthcare-associated infection". The Journal of Hospital Infection. 79 (3): 189–93. doi:10.1016/j.jhin.2011.04.028. PMID 21741111.
- Golding GR, Quinn B, Bergstrom K, Stockdale D, Woods S, Nsungu M, et al. (January 2012). "Community-based educational intervention to limit the dissemination of community-associated methicillin-resistant Staphylococcus aureus in Northern Saskatchewan, Canada". BMC Public Health. 12 (1): 15. doi:10.1186/1471-2458-12-15. PMC 3287965. PMID 22225643.
- Loewen, Kassandra; Schreiber, Yoko; Kirlew, Mike; Bocking, Natalie; Kelly, Len (July 2017). "Community-associated methicillin-resistant Staphylococcus aureus infection". Canadian Family Physician. 63 (7): 512–520. ISSN 0008-350X. PMC 5507223. PMID 28701438.
- Tacconelli E, De Angelis G, Cataldo MA, Pozzi E, Cauda R (January 2008). "Does antibiotic exposure increase the risk of methicillin-resistant Staphylococcus aureus (MRSA) isolation? A systematic review and meta-analysis". The Journal of Antimicrobial Chemotherapy. 61 (1): 26–38. doi:10.1093/jac/dkm416. PMID 17986491.
- Dumyati G, Stone ND, Nace DA, Crnich CJ, Jump RL (April 2017). "Challenges and Strategies for Prevention of Multidrug-Resistant Organism Transmission in Nursing Homes". Current Infectious Disease Reports. 19 (4): 18. doi:10.1007/s11908-017-0576-7. PMC 5382184. PMID 28382547.
- "Study: Beachgoers More Likely to Catch MRSA". FoxNews.com. Reuters. 2009-02-16.
- Marilynn Marchione (2009-09-12). "Dangerous staph germs found at West Coast beaches". Associated Press.
- Zinderman CE, Conner B, Malakooti MA, LaMar JE, Armstrong A, Bohnker BK (May 2004). "Community-acquired methicillin-resistant Staphylococcus aureus among military recruits". Emerging Infectious Diseases. 10 (5): 941–4. doi:10.3201/eid1005.030604. PMC 3323224. PMID 15200838.
- "MRSA History Timeline: The First Half-Century, 1959–2009". The University of Chicago Medical Center. 2010.
- David MZ, Daum RS (July 2010). "Community-associated methicillin-resistant Staphylococcus aureus: epidemiology and clinical consequences of an emerging epidemic". Clinical Microbiology Reviews. 23 (3): 616–87. doi:10.1128/CMR.00081-09. PMC 2901661. PMID 20610826.
- Gopal S, Divya KC (March 2017). "Staphylococcus aureus prevalence from dairy cows in India act as potential risk for community-associated infections?: A review". Veterinary World. 10 (3): 311–318. doi:10.14202/vetworld.2017.311-318. PMC 5387658. PMID 28435193.
- Ficalora R (2013). Mayo Clinic internal medicine board review. Oxford: Oxford University Press. ISBN 978-0-19-994894-9.
- Winn W (2006). Koneman's color atlas and textbook of diagnostic microbiology. Philadelphia: Lippincott Williams & Wilkins. ISBN 978-0-7817-3014-3.
- Gurusamy KS, Koti R, Toon CD, Wilson P, Davidson BR (November 2013). Gurusamy KS (ed.). "Antibiotic therapy for the treatment of methicillin-resistant Staphylococcus aureus (MRSA) in non surgical wounds". The Cochrane Database of Systematic Reviews (11): CD010427. doi:10.1002/14651858.CD010427.pub2. PMID 24242704.
- Jacobs A (2014). "Hospital-acquired methicillin-resistant Staphylococcus aureus: status and trends". Radiologic Technology. 85 (6): 623–48, quiz 649–52. PMID 25002642.
- Davis C. "Is MRSA Contagious?". Medicinenet.com. Retrieved 24 October 2017.
- Muto CA, Jernigan JA, Ostrowsky BE, Richet HM, Jarvis WR, Boyce JM, Farr BM (May 2003). "SHEA guideline for preventing nosocomial transmission of multidrug-resistant strains of Staphylococcus aureus and enterococcus". Infection Control and Hospital Epidemiology. 24 (5): 362–86. CiteSeerX 10.1.1.575.8929. doi:10.1086/502213. PMID 12785411.
- Hughes C, Tunney M, Bradley MC (November 2013). "Infection control strategies for preventing the transmission of meticillin-resistant Staphylococcus aureus (MRSA) in nursing homes for older people". The Cochrane Database of Systematic Reviews (11): CD006354. doi:10.1002/14651858.CD006354.pub4. PMC 7000924. PMID 24254890.
- "PURE Bioscience". purebio.com. Archived from the original on 2009-02-24.
- Mehndiratta PL, Bhalla P (September 2014). "Use of antibiotics in animal agriculture & emergence of methicillin-resistant Staphylococcus aureus (MRSA) clones: need to assess the impact on public health". The Indian Journal of Medical Research. 140 (3): 339–44. PMC 4248379. PMID 25366200.
- Vitale CB, Gross TL, Weese JS (December 2006). "Methicillin-resistant Staphylococcus aureus in cat and owner". Emerging Infectious Diseases. 12 (12): 1998–2000. doi:10.3201/eid1212.060725. PMC 3291366. PMID 17354344.
This article incorporates public domain material from websites or documents of the Centers for Disease Control and Prevention. - Salgado CD, Farr BM, Calfee DP (January 2003). "Community-acquired methicillin-resistant Staphylococcus aureus: a meta-analysis of prevalence and risk factors". Clinical Infectious Diseases. 36 (2): 131–9. doi:10.1086/345436. PMID 12522744.
- Kazakova SV, Hageman JC, Matava M, Srinivasan A, Phelan L, Garfinkel B, et al. (February 2005). "A clone of methicillin-resistant Staphylococcus aureus among professional football players". The New England Journal of Medicine. 352 (5): 468–75. doi:10.1056/NEJMoa042859. PMID 15689585.
- Epstein V (21 December 2007). "Texas Football Succumbs to Virulent Staph Infection From Turf". Bloomberg. Retrieved 10 June 2010.
- Yasinskas, Pat (11 October 2013). "Third Tampa Bay Buccaneers player tests positive for MRSA staph infection". ESPN. ESPN Internet Ventures. Retrieved 11 October 2013.
- Hernandez D (August 12, 2015). "Dodgers' Justin Turner nears return from MRSA infection". Los Angeles Times. Retrieved August 13, 2015.
- Rappoport I (October 11, 2015). "MRSA infection leaves Giants' Daniel Fells in dire situation". NFL.com. Retrieved October 12, 2015.
- Gray JW (April 2004). "MRSA: the problem reaches paediatrics". Archives of Disease in Childhood. 89 (4): 297–8. doi:10.1136/adc.2003.045534. PMC 1719885. PMID 15033832.
- Bratu S, Eramo A, Kopec R, Coughlin E, Ghitan M, Yost R, et al. (June 2005). "Community-associated methicillin-resistant Staphylococcus aureus in hospital nursery and maternity units". Emerging Infectious Diseases. 11 (6): 808–13. doi:10.3201/eid1106.040885. PMC 3367583. PMID 15963273.
- Association for Professionals in Infection Control & Epidemiology (June 25, 2007). "National Prevalence Study of Methicillin-Resistant Staphylococcus aureus (MRSA) in U.S. Healthcare Facilities". Archived from the original on September 7, 2007. Retrieved 2007-07-14.
- "Staph Infections and MRSA in Children: Prevention, Symptoms, and Treatment". webmd.com.
- Parikh, Meghana P.; Octaria, Rany; Kainer, Marion A. (2020). "Methicillin-Resistant Staphylococcus aureus Bloodstream Infections and Injection Drug Use, Tennessee, USA, 2015–2017 - Volume 26, Number 3—March 2020 - Emerging Infectious Diseases journal - CDC". Emerging Infectious Diseases. 26 (3). doi:10.3201/eid2603.191408. PMC 7045815. PMID 32091385. S2CID 211098414.
- Jensen SO, Lyon BR (June 2009). "Genetics of antimicrobial resistance in Staphylococcus aureus". Future Microbiology. 4 (5): 565–82. doi:10.2217/fmb.09.30. PMID 19492967.
- Chambers HF (February 2001). "Methicillin-resistant Staphylococcus aureus. Mechanisms of resistance and implications for treatment". Postgraduate Medicine. 109 (2 Suppl): 43–50. doi:10.3810/pgm.02.2001.suppl12.65 (inactive 2021-01-14). PMID 19667557.CS1 maint: DOI inactive as of January 2021 (link)
- Lowy FD (May 2003). "Antimicrobial resistance: the example of Staphylococcus aureus". The Journal of Clinical Investigation. 111 (9): 1265–73. doi:10.1172/JCI18535. PMC 154455. PMID 12727914.
- Pantosti A, Sanchini A, Monaco M (June 2007). "Mechanisms of antibiotic resistance in Staphylococcus aureus". Future Microbiology. 2 (3): 323–34. doi:10.2217/17460913.2.3.323. PMID 17661706.
- Kaito C, Saito Y, Nagano G, Ikuo M, Omae Y, Hanada Y, et al. (February 2011). Cheung A (ed.). "Transcription and translation products of the cytolysin gene psm-mec on the mobile genetic element SCCmec regulate Staphylococcus aureus virulence". PLOS Pathogens. 7 (2): e1001267. doi:10.1371/journal.ppat.1001267. PMC 3033363. PMID 21304931.
- Cheung GY, Villaruz AE, Joo HS, Duong AC, Yeh AJ, Nguyen TH, et al. (July 2014). "Genome-wide analysis of the regulatory function mediated by the small regulatory psm-mec RNA of methicillin-resistant Staphylococcus aureus". International Journal of Medical Microbiology. 304 (5–6): 637–44. doi:10.1016/j.ijmm.2014.04.008. PMC 4087065. PMID 24877726.
- Enright MC, Robinson DA, Randle G, Feil EJ, Grundmann H, Spratt BG (May 2002). "The evolutionary history of methicillin-resistant Staphylococcus aureus (MRSA)". Proceedings of the National Academy of Sciences of the United States of America. 99 (11): 7687–92. Bibcode:2002PNAS...99.7687E. doi:10.1073/pnas.122108599. PMC 124322. PMID 12032344.
- Wu SW, de Lencastre H, Tomasz A (April 2001). "Recruitment of the mecA gene homologue of Staphylococcus sciuri into a resistance determinant and expression of the resistant phenotype in Staphylococcus aureus". Journal of Bacteriology. 183 (8): 2417–24. doi:10.1128/JB.183.8.2417-2424.2001. PMC 95156. PMID 11274099.
- Kuo SC, Chiang MC, Lee WS, Chen LY, Wu HS, Yu KW, et al. (January 2012). "Comparison of microbiological and clinical characteristics based on SCCmec typing in patients with community-onset meticillin-resistant Staphylococcus aureus (MRSA) bacteraemia". International Journal of Antimicrobial Agents. 39 (1): 22–6. doi:10.1016/j.ijantimicag.2011.08.014. PMID 21982834.
- Collins J, Rudkin J, Recker M, Pozzi C, O'Gara JP, Massey RC (April 2010). "Offsetting virulence and antibiotic resistance costs by MRSA". The ISME Journal. 4 (4): 577–84. doi:10.1038/ismej.2009.151. PMID 20072161. S2CID 38231565.
- Sahebnasagh R, Saderi H, Owlia P. Detection of methicillin-resistant Staphylococcus aureus strains from clinical samples in Tehran by detection of the mecA and nuc genes. The First Iranian International Congress of Medical Bacteriology; 4–7 September; Tabriz, Iran. 2011. 195 pp.
- Berger-Bächi B (November 1999). "Genetic basis of methicillin resistance in Staphylococcus aureus". Cellular and Molecular Life Sciences. 56 (9–10): 764–70. doi:10.1007/s000180050023. PMID 11212336. S2CID 40019841. Archived from the original on 2013-02-12.
- Goering RV, McDougal LK, Fosheim GE, Bonnstetter KK, Wolter DJ, Tenover FC (June 2007). "Epidemiologic distribution of the arginine catabolic mobile element among selected methicillin-resistant and methicillin-susceptible Staphylococcus aureus isolates". Journal of Clinical Microbiology. 45 (6): 1981–4. doi:10.1128/JCM.00273-07. PMC 1933090. PMID 17409207.
- Joshi, Gauri S.; Spontak, Jeffrey S.; Klapper, David G.; Richardson, Anthony R. (2011-09-08). "Arginine catabolic mobile element encoded speG abrogates the unique hypersensitivity of Staphylococcus aureus to exogenous polyamines". Molecular Microbiology. Wiley. 82 (1): 9–20. doi:10.1111/j.1365-2958.2011.07809.x. ISSN 0950-382X. PMC 3183340. PMID 21902734.
- Gordon RJ, Lowy FD (June 2008). "Pathogenesis of methicillin-resistant Staphylococcus aureus infection". Clinical Infectious Diseases. 46 Suppl 5 (Suppl 5): S350-9. doi:10.1086/533591. PMC 2474459. PMID 18462090.
- Johnson AP, Aucken HM, Cavendish S, Ganner M, Wale MC, Warner M, et al. (July 2001). "Dominance of EMRSA-15 and -16 among MRSA causing nosocomial bacteraemia in the UK: analysis of isolates from the European Antimicrobial Resistance Surveillance System (EARSS)". The Journal of Antimicrobial Chemotherapy. 48 (1): 143–4. doi:10.1093/jac/48.1.143. PMID 11418528.
- Diep BA, Carleton HA, Chang RF, Sensabaugh GF, Perdreau-Remington F (June 2006). "Roles of 34 virulence genes in the evolution of hospital- and community-associated strains of methicillin-resistant Staphylococcus aureus". The Journal of Infectious Diseases. 193 (11): 1495–503. doi:10.1086/503777. PMID 16652276.
- Stefani S, Chung DR, Lindsay JA, Friedrich AW, Kearns AM, Westh H, Mackenzie FM (April 2012). "Meticillin-resistant Staphylococcus aureus (MRSA): global epidemiology and harmonisation of typing methods". International Journal of Antimicrobial Agents. 39 (4): 273–82. doi:10.1016/j.ijantimicag.2011.09.030. PMID 22230333.
- Calfee DP (2011). "The epidemiology, treatment, and prevention of transmission of methicillin-resistant Staphylococcus aureus". Journal of Infusion Nursing. 34 (6): 359–64. doi:10.1097/NAN.0b013e31823061d6. PMID 22101629. S2CID 11490852.
- Daum RS (July 2007). "Clinical practice. Skin and soft-tissue infections caused by methicillin-resistant Staphylococcus aureus". The New England Journal of Medicine. 357 (4): 380–90. doi:10.1056/NEJMcp070747. PMID 17652653.
- Wang R, Braughton KR, Kretschmer D, Bach TH, Queck SY, Li M, et al. (December 2007). "Identification of novel cytolytic peptides as key virulence determinants for community-associated MRSA". Nature Medicine. 13 (12): 1510–4. doi:10.1038/nm1656. PMID 17994102. S2CID 8465052.
- Tristan A, Bes M, Meugnier H, Lina G, Bozdogan B, Courvalin P, et al. (April 2007). "Global distribution of Panton-Valentine leukocidin--positive methicillin-resistant Staphylococcus aureus, 2006". Emerging Infectious Diseases. 13 (4): 594–600. doi:10.3201/eid1304.061316. PMC 2725977. PMID 17553275.
- Gould IM, David MZ, Esposito S, Garau J, Lina G, Mazzei T, Peters G (February 2012). "New insights into meticillin-resistant Staphylococcus aureus (MRSA) pathogenesis, treatment and resistance". International Journal of Antimicrobial Agents. 39 (2): 96–104. doi:10.1016/j.ijantimicag.2011.09.028. PMID 22196394.
- David MZ, Rudolph KM, Hennessy TW, Boyle-Vavra S, Daum RS (November 2008). "Molecular epidemiology of methicillin-resistant Staphylococcus aureus, rural southwestern Alaska". Emerging Infectious Diseases. 14 (11): 1693–9. doi:10.3201/eid1411.080381. PMC 2630737. PMID 18976551.
- Panel on Biological Hazards (16 June 2009). "Joint scientific report of ECDC, EFSA and EMEA on meticillin resistant Staphylococcus aureus (MRSA) in livestock, companion animals and food". EFSA Journal. 7 (6). doi:10.2903/j.efsa.2009.301r.
- Graveland H, Duim B, van Duijkeren E, Heederik D, Wagenaar JA (December 2011). "Livestock-associated methicillin-resistant Staphylococcus aureus in animals and humans". International Journal of Medical Microbiology. 301 (8): 630–4. doi:10.1016/j.ijmm.2011.09.004. PMID 21983338.
- Francois P, Schrenzel J (2008). "Rapid Diagnosis and Typing of Staphylococcus aureus". Staphylococcus: Molecular Genetics. Caister Academic Press. ISBN 978-1-904455-29-5.
- Mackay IM, ed. (2007). Real-Time PCR in Microbiology: From Diagnosis to Characterization. Caister Academic Press. ISBN 978-1-904455-18-9.
- Seiken D. "MRSA latex test for PBP2".
- Murray P (2007). Manual of clinical microbiology. Washington, D.C: ASM Press. ISBN 978-1-55581-371-0.
- Tacconelli E, De Angelis G, de Waure C, Cataldo MA, La Torre G, Cauda R (September 2009). "Rapid screening tests for meticillin-resistant Staphylococcus aureus at hospital admission: systematic review and meta-analysis". The Lancet. Infectious Diseases. 9 (9): 546–54. doi:10.1016/S1473-3099(09)70150-1. PMID 19695491.
- McCaughey B. "Unnecessary Deaths: The Human and Financial Costs of Hospital Infections" (PDF) (2nd ed.). Archived from the original (PDF) on July 11, 2007. Retrieved 2007-08-05.
- "Personal Prevention of MRSA Skin Infections". CDC. 9 August 2010. Retrieved 25 May 2017.
This article incorporates public domain material from websites or documents of the Centers for Disease Control and Prevention. - "NIOSH MRSA and the Workplace". United States National Institute for Occupational Safety and Health. Retrieved 2017-05-25.
- CDC (1998). "Guidelines for Infection Control in Health Care Personnel, 1998". Centers for Disease Control and Prevention. Retrieved December 18, 2007.
- Banach DB, Bearman G, Barnden M, Hanrahan JA, Leekha S, Morgan DJ, et al. (February 2018). "Duration of Contact Precautions for Acute-Care Settings". Infection Control and Hospital Epidemiology. 39 (2): 127–144. doi:10.1017/ice.2017.245. PMID 29321078.
- "Living With MRSA" (PDF). Group Health Cooperative/Tacoma-Pierce County Health Dept./Washington State Dept. of Health. Retrieved 20 November 2011.
- Cooper BS, Medley GF, Stone SP, Kibbler CC, Cookson BD, Roberts JA, et al. (July 2004). "Methicillin-resistant Staphylococcus aureus in hospitals and the community: stealth dynamics and control catastrophes". Proceedings of the National Academy of Sciences of the United States of America. 101 (27): 10223–8. Bibcode:2004PNAS..10110223C. doi:10.1073/pnas.0401324101. PMC 454191. PMID 15220470.
- Bootsma MC, Diekmann O, Bonten MJ (April 2006). "Controlling methicillin-resistant Staphylococcus aureus: quantifying the effects of interventions and rapid diagnostic testing". Proceedings of the National Academy of Sciences of the United States of America. 103 (14): 5620–5. Bibcode:2006PNAS..103.5620B. doi:10.1073/pnas.0510077103. PMC 1459403. PMID 16565219.
- "MRSA (Methicillin-Resistant Staphylococcus aureus)". National Library of Medicine – PubMed Health. US National Institutes of Health. Retrieved 20 November 2011.
- Shi CM, Nakao H, Yamazaki M, Tsuboi R, Ogawa H (November 2007). "Mixture of sugar and povidone-iodine stimulates healing of MRSA-infected skin ulcers on db/db mice". Archives of Dermatological Research. 299 (9): 449–56. doi:10.1007/s00403-007-0776-3. PMID 17680256. S2CID 28807435.
- "The Workplace (Health, Safety and Welfare) Regulations 1992". UK legislation. The National Archives/Her Majesty’s Stationery Office. Retrieved January 12, 2018.
- Foundation, Internet Memory. "[ARCHIVED CONTENT] UK Government Web Archive – The National Archives". Archived from the original on 2012-09-19.CS1 maint: bot: original URL status unknown (link)
- "Government Response to the Communities and Local Government Committee Report on the Provision of Public Toilets". Archived from the original on 2012-09-19.
- Gurusamy KS, Koti R, Toon CD, Wilson P, Davidson BR (November 2013). Gurusamy KS (ed.). "Antibiotic therapy for the treatment of methicillin-resistant Staphylococcus aureus (MRSA) in non surgical wounds". The Cochrane Database of Systematic Reviews (11): CD010427. doi:10.1002/14651858.CD010427. PMID 24242704.
- Choo EJ, Chambers HF (December 2016). "Treatment of Methicillin-Resistant Staphylococcus aureus Bacteremia". Infection & Chemotherapy. 48 (4): 267–273. doi:10.3947/ic.2016.48.4.267. PMC 5204005. PMID 28032484.
- Yue J, Dong BR, Yang M, Chen X, Wu T, Liu GJ (January 2016). "Linezolid versus vancomycin for skin and soft tissue infections". The Cochrane Database of Systematic Reviews (1): CD008056. doi:10.1002/14651858.CD008056.pub3. PMID 26758498.
- "FDA Approves Teflaro for Bacterial Infections".
- Schentag JJ, Hyatt JM, Carr JR, Paladino JA, Birmingham MC, Zimmer GS, Cumbo TJ (May 1998). "Genesis of methicillin-resistant Staphylococcus aureus (MRSA), how treatment of MRSA infections has selected for vancomycin-resistant Enterococcus faecium, and the importance of antibiotic management and infection control". Clinical Infectious Diseases. 26 (5): 1204–14. doi:10.1086/520287. PMID 9597254.
- Rybak MJ, Lerner SA, Levine DP, Albrecht LM, McNeil PL, Thompson GA, et al. (April 1991). "Teicoplanin pharmacokinetics in intravenous drug abusers being treated for bacterial endocarditis". Antimicrobial Agents and Chemotherapy. 35 (4): 696–700. doi:10.1128/AAC.35.4.696. PMC 245081. PMID 1829880.
- Janknegt R (June 1997). "The treatment of staphylococcal infections with special reference to pharmacokinetic, pharmacodynamic and pharmacoeconomic considerations". Pharmacy World & Science. 19 (3): 133–41. doi:10.1023/A:1008609718457. PMID 9259029. S2CID 10413339.
- Chang FY, Peacock JE, Musher DM, Triplett P, MacDonald BB, Mylotte JM, et al. (September 2003). "Staphylococcus aureus bacteremia: recurrence and the impact of antibiotic treatment in a prospective multicenter study". Medicine. 82 (5): 333–9. doi:10.1097/01.md.0000091184.93122.09. PMID 14530782. S2CID 15917805.
- Siegman-Igra Y, Reich P, Orni-Wasserlauf R, Schwartz D, Giladi M (2005). "The role of vancomycin in the persistence or recurrence of Staphylococcus aureus bacteraemia". Scandinavian Journal of Infectious Diseases. 37 (8): 572–578. doi:10.1080/00365540510038488. PMID 16138425. S2CID 24390948.
- Sieradzki K, Tomasz A (April 1997). "Inhibition of cell wall turnover and autolysis by vancomycin in a highly vancomycin-resistant mutant of Staphylococcus aureus". Journal of Bacteriology. 179 (8): 2557–66. doi:10.1128/jb.179.8.2557-2566.1997. PMC 179004. PMID 9098053.
- Schito GC (March 2006). "The importance of the development of antibiotic resistance in Staphylococcus aureus". Clinical Microbiology and Infection. 12 Suppl 1 (Suppl 1): 3–8. doi:10.1111/j.1469-0691.2006.01343.x. PMID 16445718.
- Mongkolrattanothai K, Boyle S, Kahana MD, Daum RS (October 2003). "Severe Staphylococcus aureus infections caused by clonally related community-acquired methicillin-susceptible and methicillin-resistant isolates". Clinical Infectious Diseases. 37 (8): 1050–8. doi:10.1086/378277. PMID 14523769.
- Bozdogan B, Esel D, Whitener C, Browne FA, Appelbaum PC (November 2003). "Antibacterial susceptibility of a vancomycin-resistant Staphylococcus aureus strain isolated at the Hershey Medical Center". The Journal of Antimicrobial Chemotherapy. 52 (5): 864–8. doi:10.1093/jac/dkg457. PMID 14563898.
- Xie J, Pierce JG, James RC, Okano A, Boger DL (September 2011). "A redesigned vancomycin engineered for dual D-Ala-D-ala And D-Ala-D-Lac binding exhibits potent antimicrobial activity against vancomycin-resistant bacteria". Journal of the American Chemical Society. 133 (35): 13946–9. doi:10.1021/ja207142h. PMC 3164945. PMID 21823662.
- Tsiodras S, Gold HS, Sakoulas G, Eliopoulos GM, Wennersten C, Venkataraman L, et al. (July 2001). "Linezolid resistance in a clinical isolate of Staphylococcus aureus". Lancet. 358 (9277): 207–8. doi:10.1016/S0140-6736(01)05410-1. PMID 11476839. S2CID 27426801.
- Hope R, Livermore DM, Brick G, Lillie M, Reynolds R (November 2008). "Non-susceptibility trends among staphylococci from bacteraemias in the UK and Ireland, 2001-06" (PDF). The Journal of Antimicrobial Chemotherapy. 62 Suppl 2: ii65-74. doi:10.1093/jac/dkn353. PMID 18819981.
- Maselli DJ, Keyt H, Restrepo MI (May 2017). "Inhaled Antibiotic Therapy in Chronic Respiratory Diseases". International Journal of Molecular Sciences. 18 (5): 1062. doi:10.3390/ijms18051062. PMC 5454974. PMID 28509852.
- Loeb MB, Main C, Eady A, Walker-Dilks C, et al. (Cochrane Wounds Group) (2003-10-20). "Antimicrobial drugs for treating methicillin-resistant Staphylococcus aureus colonization". The Cochrane Database of Systematic Reviews (4): CD003340. doi:10.1002/14651858.CD003340. PMID 14583969.
- "MRSA Infections". Keep Kids Healthy. Archived from the original on December 9, 2007.
- Fritz SA, Garbutt J, Elward A, Shannon W, Storch GA (June 2008). "Prevalence of and risk factors for community-acquired methicillin-resistant and methicillin-sensitive staphylococcus aureus colonization in children seen in a practice-based research network". Pediatrics. 121 (6): 1090–8. doi:10.1542/peds.2007-2104. PMID 18519477. S2CID 23112235.
- Klein EY, Sun L, Smith DL, Laxminarayan R (April 2013). "The changing epidemiology of methicillin-resistant Staphylococcus aureus in the United States: a national observational study". American Journal of Epidemiology. 177 (7): 666–74. doi:10.1093/aje/kws273. PMID 23449778.
- "Antibiotic Resistance Threats in the United States, 2013 – Antibiotic/Antimicrobial Resistance – CDC". 2019-05-07.
This article incorporates public domain material from websites or documents of the Centers for Disease Control and Prevention. - "ResistanceMap – Antibiotic Resistance". resistancemap.cddep.org. Center for Disease Dynamics, Economics & Policy. 2017. Retrieved 27 May 2017. note: a search must be performed on the website; it is interactive and the statistics are based upon the most current information,
- Klevens RM, Edwards JR, Richards CL, Horan TC, Gaynes RP, Pollock DA, Cardo DM (2007). "Estimating health care-associated infections and deaths in U.S. hospitals, 2002". Public Health Reports. 122 (2): 160–6. doi:10.1177/003335490712200205. PMC 1820440. PMID 17357358.
- Hidron AI, Edwards JR, Patel J, Horan TC, Sievert DM, Pollock DA, Fridkin SK (November 2008). "NHSN annual update: antimicrobial-resistant pathogens associated with healthcare-associated infections: annual summary of data reported to the National Healthcare Safety Network at the Centers for Disease Control and Prevention, 2006-2007". Infection Control and Hospital Epidemiology. 29 (11): 996–1011. doi:10.1086/591861. PMID 18947320.
- Johnson AP, Pearson A, Duckworth G (September 2005). "Surveillance and epidemiology of MRSA bacteraemia in the UK". The Journal of Antimicrobial Chemotherapy. 56 (3): 455–62. doi:10.1093/jac/dki266. PMID 16046464.
- Graham PL, Lin SX, Larson EL (March 2006). "A U.S. population-based survey of Staphylococcus aureus colonization". Annals of Internal Medicine. 144 (5): 318–25. doi:10.7326/0003-4819-144-5-200603070-00006. PMID 16520472. S2CID 38816447.
- Jernigan JA, Arnold K, Heilpern K, Kainer M, Woods C, Hughes JM (2006-05-12). "Methicillin-resistant Staphylococcus aureus as community pathogen". Symposium on Community-Associated Methicillin-resistant Staphylococcus aureus (Atlanta, Georgia, U.S.). Cited in Emerg Infect Dis. Centers for Disease Control and Prevention. Retrieved 2007-01-27.
- "Community-acquired MRSA in Children with no predisposing risk" (PDF).
- Holden MT, Feil EJ, Lindsay JA, Peacock SJ, Day NP, Enright MC, et al. (June 2004). "Complete genomes of two clinical Staphylococcus aureus strains: evidence for the rapid evolution of virulence and drug resistance". Proceedings of the National Academy of Sciences of the United States of America. 101 (26): 9786–91. Bibcode:2004PNAS..101.9786H. doi:10.1073/pnas.0402521101. PMC 470752. PMID 15213324.
- Blot SI, Vandewoude KH, Hoste EA, Colardyn FA (October 2002). "Outcome and attributable mortality in critically Ill patients with bacteremia involving methicillin-susceptible and methicillin-resistant Staphylococcus aureus". Archives of Internal Medicine. 162 (19): 2229–35. doi:10.1001/archinte.162.19.2229. PMID 12390067.
- Liu C, Graber CJ, Karr M, Diep BA, Basuino L, Schwartz BS, et al. (June 2008). "A population-based study of the incidence and molecular epidemiology of methicillin-resistant Staphylococcus aureus disease in San Francisco, 2004-2005". Clinical Infectious Diseases. 46 (11): 1637–46. doi:10.1086/587893. PMID 18433335.
- Noskin GA, Rubin RJ, Schentag JJ, Kluytmans J, Hedblom EC, Smulders M, et al. (2005). "The burden of Staphylococcus aureus infections on hospitals in the United States: an analysis of the 2000 and 2001 Nationwide Inpatient Sample Database". Archives of Internal Medicine. 165 (15): 1756–61. doi:10.1001/archinte.165.15.1756. PMID 16087824.
- Cosgrove SE, Qi Y, Kaye KS, Harbarth S, Karchmer AW, Carmeli Y (February 2005). "The impact of methicillin resistance in Staphylococcus aureus bacteremia on patient outcomes: mortality, length of stay, and hospital charges". Infection Control and Hospital Epidemiology. 26 (2): 166–74. doi:10.1086/502522. PMID 15756888.
- Hardy KJ, Hawkey PM, Gao F, Oppenheim BA (January 2004). "Methicillin resistant Staphylococcus aureus in the critically ill". British Journal of Anaesthesia. 92 (1): 121–30. doi:10.1093/bja/aeh008. PMID 14665563.
- Wyllie DH, Crook DW, Peto TE (August 2006). "Mortality after Staphylococcus aureus bacteraemia in two hospitals in Oxfordshire, 1997-2003: cohort study". BMJ. 333 (7562): 281. doi:10.1136/bmj.38834.421713.2F. PMC 1526943. PMID 16798756.
- "Healthcare-associated infections—HAI—CDC" (PDF). cdc.gov. 2019-06-03.
- "MRSA Surveillance". Centers for Disease Control and Prevention. April 8, 2011.
- "Outcomes in EHCI 2015" (PDF). Health Consumer Powerhouse. 26 January 2016. Archived from the original (PDF) on 6 June 2017. Retrieved 27 January 2016.
- Thompson N, Smith-Spark L. "Thousand-year-old Anglo-Saxon potion kills MRSA superbug". CNN News. CNN/Time Warner. Retrieved 1 April 2015.
- "Bucs' Nicks, Tynes have MRSA infections". Tampa Bay Times. Retrieved 3 June 2017.
- Correspondent, Elizabeth Cohen, Senior Medical. "MRSA: The tiny bacteria that can tackle giants". CNN. Retrieved 3 June 2017.
- Biddle S, Cush A. "This Australian Says He and His Dead Friend Invented Bitcoin". Retrieved 3 June 2017.
- Singh J, Johnson RC, Schlett CD, Elassal EM, Crawford KB, Mor D, et al. (2016-10-26). "Multi-Body-Site Microbiome and Culture Profiling of Military Trainees Suffering from Skin and Soft Tissue Infections at Fort Benning, Georgia". mSphere. 1 (5): e00232–16. doi:10.1128/mSphere.00232-16. PMC 5064451. PMID 27747300.
- "Hospital Infection Lawsuits are on the Rise – AboutLawsuits.com". www.aboutlawsuits.com. Retrieved 3 June 2017.
- "Doc who treated superbug vic was sued before". Retrieved 3 June 2017.
- "MRSA: The Drug-Resistant 'Superbug' That Won't Die". NPR.org. Retrieved 3 June 2017.
- ""Should I Worry About...?" MRSA (TV Episode 2004)". Retrieved 3 June 2017.
- McKenna M. "Resistance: The Movie That Will Make You Care About Antibiotic Misuse". Retrieved 3 June 2017.
- "Line of Duty series 4: Everything you need to know". 24 April 2017. Retrieved 3 June 2017.
- results, search (1 February 2011). Superbug: The Fatal Menace of MRSA. Free Press. ISBN 978-1-4165-5728-9.
- "Facing the Future of Antibiotic Resistance – The Change Starts Here". HuffPost UK. Retrieved 3 June 2017.
- Lingbeck JM, O'Bryan CA, Martin EM, Adams JP, Crandall PG (2015). "Sweetgum: An ancient source of beneficial compounds with modern benefits". Pharmacognosy Reviews. 9 (17): 1–11. doi:10.4103/0973-7847.156307. PMC 4441155. PMID 26009686.
- Reardon S (June 2014). "Phage therapy gets revitalized". Nature. 510 (7503): 15–6. Bibcode:2014Natur.510...15R. doi:10.1038/510015a. PMID 24899282. S2CID 205081324.
- Robson D. "The viruses that may save humanity". Retrieved 2018-09-25.
- "The Next SpaceX Launch Will Carry Deadly Bacteria". 7 February 2017. Retrieved 3 June 2017.
- "KDC Projects". www.kdcprojects.com. Retrieved 3 June 2017.
- López-Alcalde J, Mateos-Mazón M, Guevara M, Conterno LO, Solà I, Cabir Nunes S, Bonfill Cosp X (July 2015). "Gloves, gowns and masks for reducing the transmission of meticillin-resistant Staphylococcus aureus (MRSA) in the hospital setting". The Cochrane Database of Systematic Reviews (7): CD007087. doi:10.1002/14651858.cd007087.pub2. PMC 7026606. PMID 26184396.
Further reading
| Wikimedia Commons has media related to MRSA. |
- The Centers for Disease Control and Prevention information, prevention, statistics, at risk groups, causes, educational resources, and environmental factors.
- National Institute for Occupational Safety and Health information on the bacteria, exposure in the workplace, and reducing risks of being infected.